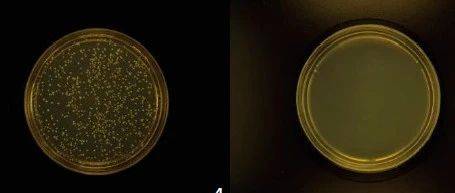

《复合材料学报》优先在线发表论文。
摘 要:以一步原位聚合法制备芯材为环氧树脂(E-51),壁材为脲醛树脂(UF)的E-51-UF微胶囊。采用FTIR、SEM、TG、粒度分析仪等分别对E-51-UF微胶囊结构、表面形貌、耐热性和粒径分布进行了表征。以E-51-UF微胶囊为核,固化剂2-甲基咪唑(2-MI)为壳通过共混复合,得到E-51-UF@2-MI复合微胶囊。将该E-51-UF@2-MI微胶囊填充到环氧树脂基体中,制备了E-51-UF@2-MI微胶囊/环氧树脂复合材料拉伸、弯曲试样和梯形双悬臂梁(TDCB)修复试样,并采用电子万能试验机测试试样性能。分析了填充E-51-UF@2-MI微胶囊质量分数对E-51-UF@2-MI微胶囊/环氧树脂复合材料力学性能及自修复性能的影响。结果表明:制备的E-51-UF微胶囊呈现规整球形结构,平均粒径为130 μm,耐热温度达364℃;填充10wt%的E-51-UF@2-MI复合微胶囊时,E-51-UF@2-MI微胶囊/环氧树脂复合材料拉伸强度达到最大值31.17 MPa,弯曲强度66.77 MPa,最大修复率为90.1%。
关键词:一步原位聚合法;环氧树脂;复合微胶囊;复合材料;2-甲基咪唑;梯形双悬臂梁;修复率
Abstract: The E-51-UF microcapsules were synthesized by one-step in-situ polymerization with urea-formaldehy de(UF) resin as the shell and epoxy resin (E-51) as the core material. The structure, surface morphology, heat resistance and particle size distribution of E-51-UF microcapsules were characterized by FTIR, SEM, TG and particle size analyzer. The E-51-UF@2-MI composite microcapsules were prepared by blending E-51-UF microcapsules as the core and 2-methylimidazole (2-MI) as the shell. The E-51-UF@2-MI composite microcapsules were filled in the epoxy resin matrix and E-51-UF@2-MI microcapsules/epoxy resin composite samples were prepared for the tensile, bending and trapezoidal double cantilever beam (TDCB), the electronic universal testing machine was used to test the properties of the samples. The effects of the mass fraction of E-51-UF@2-MI composite microcapsules on the mechanical properties and self-healing properties of E-51-UF@2-MI microcapsules/epoxy resin composites were analyzed. The results show that the prepared E-51-UF microcapsules have a regular spherical structure with an average particle size of 130 μm and a heat resistant temperature of 364℃. When the mass fraction of E-51-UF@2-MI microcapsules filled in the epoxy resin matrix is 10 wt%, the tensile strength of E-51-UF@2-MI composite microcapsules/epoxy resin compositess reaches a maximum of 31.17 MPa, the bending strength is 66.77 MPa and the maximum self-healing ratio is 90.1%.
Keywords: one-step in-situ polymerization; epoxy resin; composite microcapsule; composites; 2-methylimidazole; trapezoidal double cantilever beam; self-healing ratio
作者:肖春平等,南昌航空大学 材料学院,南昌
通讯作者:万里鹰,南昌航空大学 材料学院,南昌
全文详见中国知网学术期刊优先数字出版。

来源:CSCM_OFFICE 中国复合材料学会
原文链接:https://mp.weixin.qq.com/s?__biz=MjM5MTA2NTk1Nw==&mid=2654408744&idx=4&sn=cf8208ef05e066baf7aa6ea387909afc&scene=0#wechat_redirect
版权声明:除非特别注明,本站所载内容来源于互联网、微信公众号等公开渠道,不代表本站观点,仅供参考、交流、公益传播之目的。转载的稿件版权归原作者或机构所有,如有侵权,请联系删除。
电话:(010)86409582
邮箱:kejie@scimall.org.cn